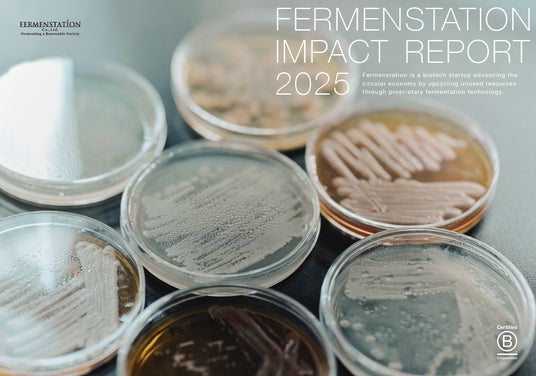

ファーメンステーション インパクトレポート2025年版
■「インパクトレポート2025」公開にあたり
当社は創業以来、事業性と社会性の両立を目指し、その両面でポジティブなインパクトの創出を追求してまいりました。2025年度版では、食領域への事業拡張、B Corp更新など一年の活動を振り返り、事業活動と社会性の両立における葛藤、組織的かつ体系的なインパクト追求の模索など、試行錯誤のプロセスを含めて開示しています。
2025年、食領域への事業拡張により、当社が取り扱うべき課題やインパクトはより深いものとなりました。資源循環型社会の実現を見据えながら、食領域のインパクト創出を取り扱う、簡単ではない道のりを具体化するための基盤整備を進めた1年となりました。
今後は、インパクト創出をより組織的に、体系立てて推進すること、ポジティブインパクトと同等に当社のネガティブインパクトを把握し改善することで、より本質的なインパクト創出を実現して参ります。
■代表コメント(代表取締役:酒井 里奈)
世の中の先行きに対して不安に思うことが多い昨今です。
そんな中でも、ファーメンステーションは変わらず、真摯に、希望を持って事業に向き合い
未利用資源から価値を生み出し、事業性と社会性を両立するチャレンジを続けています。
このレポートは、私たちがどのようなインパクトを目指し、またその過程でどのような葛藤や試行錯誤を重ねてきたかを記録しています。是非、読んでいただき、ご意見など伺えたら幸いです。
■「インパクトレポート2025」の概要
主なコンテンツは下記の通りです。
1. はじめに
2. パーパス
3. 特別対談:鳥居 希氏(バリューブックス代表取締役・B Market Builder Japan共同代表)×酒井里奈
4. ファーメンステーションについて:創業ストーリー/取り組む社会課題/課題解決アプローチ/事業について/技術について/組織・バリュー/ステークホルダーetc…
5. インパクトの進捗:B Corp更新/IMMの進捗/今後について
6. サマリー:2025年のハイライト/数字で見るファーメンステーション/年間トピックス

(レポート誌面より抜粋)
「インパクトレポート2025」は、下記URLよりご覧ください。
https://fermenstation.co.jp/report/
■ファーメンステーションの技術と事業共創について
昨今、食品ロス/食品製造工程で生じる残さ・余剰農産物などをはじめとした未利用バイオマスの有効活用は、持続可能な未来に向けたグローバルな課題です。
しかし、それぞれに多種多様な特徴を持つ未利用バイオマスと、目的の機能や特性を有するアップサイクル素材(化粧品・食品原料)を結びつける手段は豊富ではありません。
ファーメンステーションでは多様な微生物を駆使した高度な発酵技術を活用して、パートナー企業と共に食品・飲料工場の製造過程等で出る副産物・食品残さ等の未利用バイオマスを高付加価値な機能性バイオ素材へとアップサイクルする事業共創を展開しております。
技術に関する詳細はこちら
https://fermenstation.co.jp/technology/
事業共創に関する詳細はこちら
https://fermenstation.co.jp/collabo/
<株式会社ファーメンステーションについて>
ファーメンステーションは「Fermenting a Renewable Society(発酵で楽しい社会を!)」をパーパスに、未利用資源を再生・循環させる社会の構築を目指すバイオものづくりスタートアップです。独自の未利用バイオマス・微生物データベースと発酵アップサイクル技術を活用し、フードロス/ウェイストおよびその他未利用バイオマス由来のバイオ素材を開発・製造しています。発酵アップサイクル技術の基盤と、開発するアップサイクル原料をもとに、化粧品等の原料製造・販売を行う「原料事業」、パートナー企業と共創し食品・飲料工場の製造過程等で出る副産物・食品残さ等をアップサイクルしたバイオ素材等を開発する「事業共創」等を展開しています。
岩手県奥州市に自社工場を持つことで、開発から製造まで一気通貫で対応可能であり、製造過程で生じる発酵副産物を化粧品原料や飼料、肥料として利用することで、可能な限り廃棄物を少なくする循環型モデルを構築しています。
また、地域社会、環境、カスタマー、従業員に対して多面的・包括的な利益を生む事業活動を実践する企業を認証する国際的な制度「B Corp 認証」を取得しており、経済産業省から「J-Startup」「J-Startup Impact」に選定されています。
会社名 : 株式会社ファーメンステーション / Fermenstation Co.,Ltd.
代表者 : 代表取締役 酒井 里奈
所在地 : 〒273-0864 千葉県船橋市北本町1丁目17番25号
事業内容 : 発酵アップサイクル技術を活用した未利用バイオマス(フードロス等)由来のバイオ素材の研究開発および製造販売、独自技術・ノウハウを活用した事業共創・共同研究開発、アップサイクル原料を活用した化粧品・雑貨OEM/ODM
コーポレートサイト :https://fermenstation.co.jp/
事業共創 :https://fermenstation.co.jp/collabo/
技術 :https://fermenstation.co.jp/technology/
このニュースに関するお問い合わせは、下記までお願いいたします。
株式会社ファーメンステーション 渡辺 麻貴
E-mail:info@fermenstation.jp









